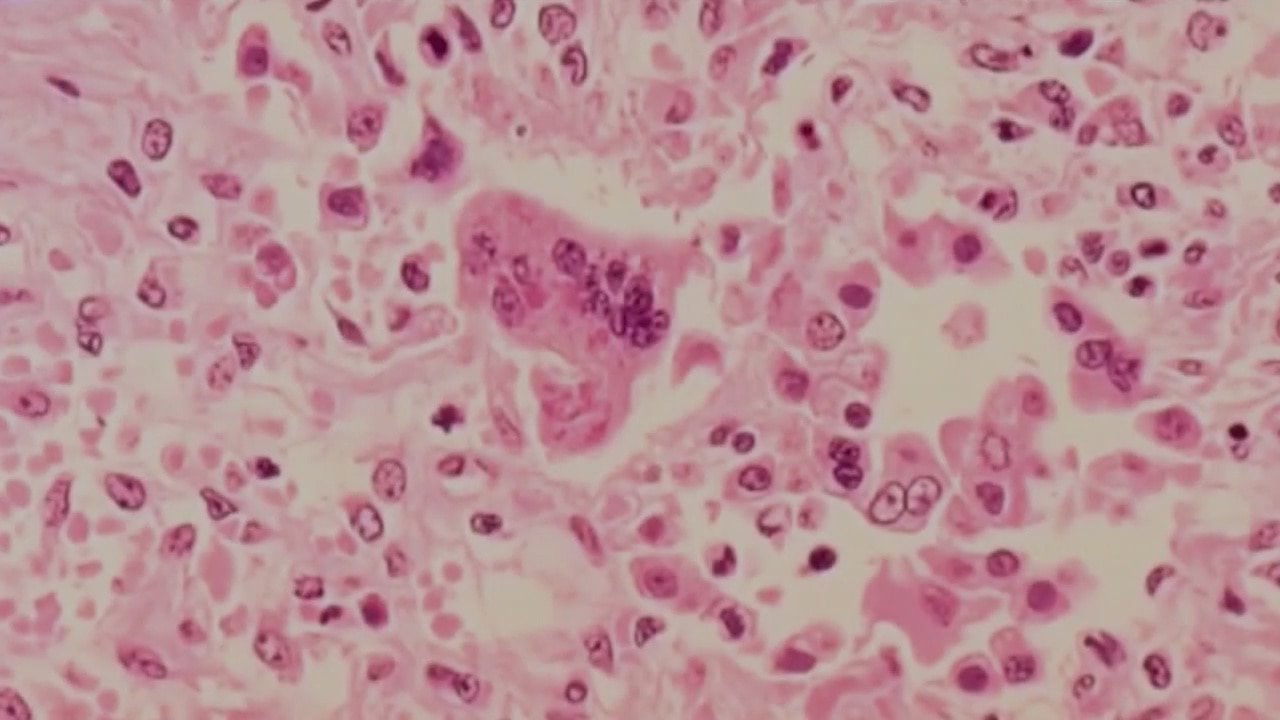

Health officials confirm measles in Los Angeles County, Long Beach, Orange County
Officials are investigating another confirmed case of measles in a Los Angeles County resident and an additional non-resident measles case who traveled throughout Southern California, part of a renewed outbreak of the disease nationally and across the Southland.
Top Videos
Health officials confirm measles in Los Angeles County, Long Beach, Orange County

LAPD: D4vd arrested for murder of Celeste Rivas Hernandez

Teachers at Little Lake City schools go on a strike

US ready to hit Iran with ‘financial equivalent’ to bombings

LAPD investigating string of burglaries in Valley Glen

42,000 UC workers to begin strike May 14

Little Lake City School District teachers strike begins

Clippers fall to Warriors in play-in tournament

Teen shot near middle school in North Hills | FOX 11 LA

Spencer Pratt appears on Joe Rogan's podcast

USC student hit in eye by DHS during 'No Kings' protest

FBI raids Lancaster City Hall, homes of top officials

Submit your name ideas for Jackie and Shadow's new eaglets

Neon green Corvette leads police chase

Neighbors frustrated with crime at vacant building

D4vd arrested in connection to murder of Celeste Rivas Hernandez

Pursuit suspect drives on rims

Cleanup planned for public nuisance property

Stolen truck pursuit leads to Santa Clarita Valley

Stolen truck pursuit leads to Santa Clarita Valley

LAPD in pursuit of stolen truck in San Fernando Valley

LAPD chasing stolen truck in LA County

Trump: Israel and Lebanon agree to 10-day ceasefire

Little Lake City School District strike underway

Political battle over homeless encampments
